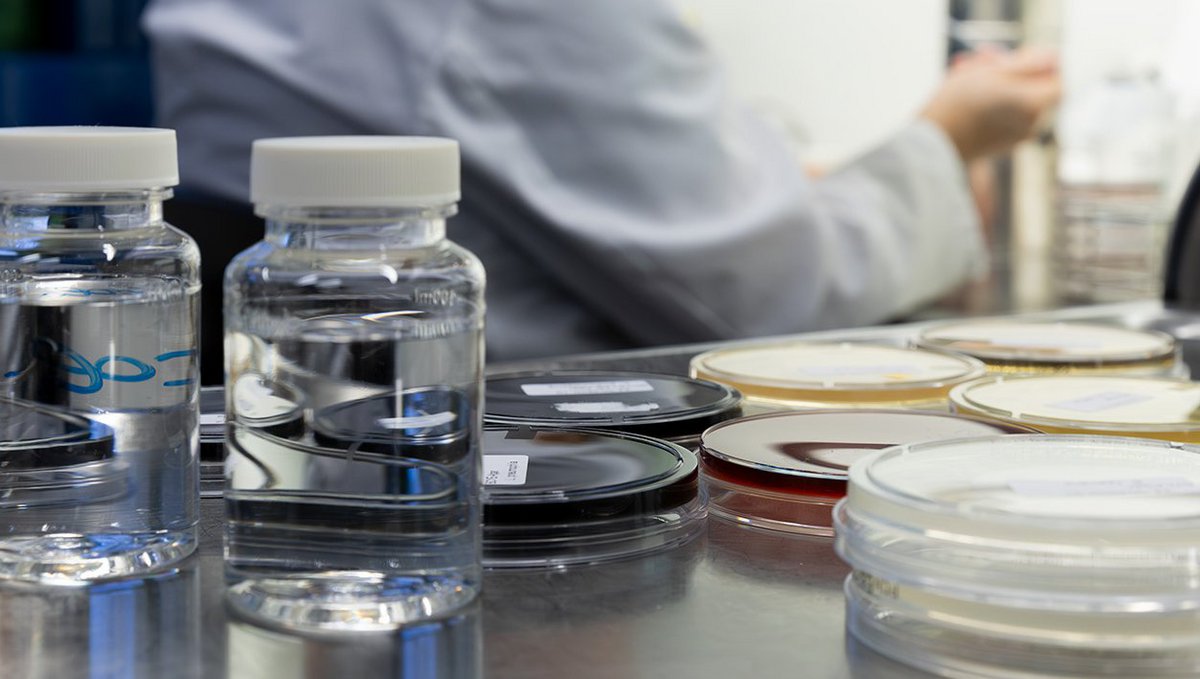

25 Jahre WWU - ein Jubiläum, das für Verlässlichkeit, Fachkompetenz und partnerschaftliches Handeln steht
Mit Wasser kennen wir uns aus
Mit modernster Ausstattung in unseren biologischen und chemischen Laboren sind wir spezialisiert auf die Untersuchung von Grundwasser, Oberflächenwasser und Trinkwasser. Zudem zählt zu unserem Kerngeschäft die Kontrolle von Roh- und Reinwasser sowie für die Trinkwasseraufbereitung relevanter Aufbereitungsstoffe.
Wir sind für die Untersuchung nahezu aller Parameter der Trinkwasserverordnung akkreditiert und bieten Probenahme und Analytik in höchster Qualität.
Neben unserer analytischen Arbeit haben wir uns auch die Beratung und Begleitung unserer Kunden, auch in herausfordernden Situationen, zur Aufgabe gemacht. Die Bedürfnisse unserer Kunden bestimmen unser tägliches Handeln. Wir entlasten und unterstützen bei Meldungen, Begehungen von technischen Anlagen, Behördenanfragen und der Öffentlichkeitsarbeit.
Unser Angebot